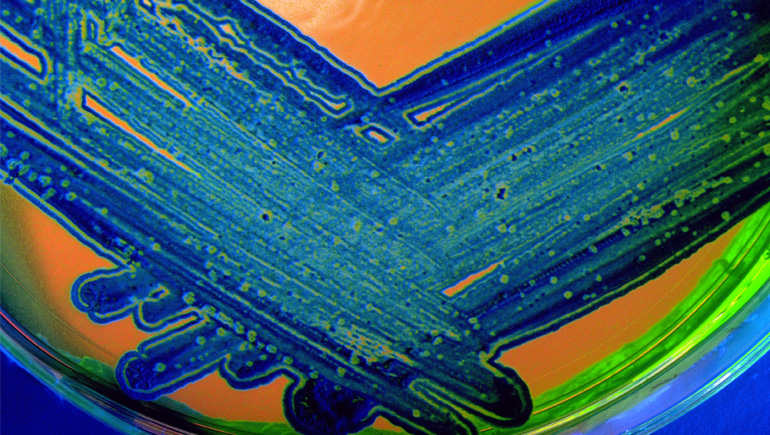

Fouad Namouni, M.D., Head of Oncology Development
In the mid-1800s, scientist Louis Pasteur was one of the first to show that germs caused illness. Before that, people didn’t understand infections.
At that time, people thought about a lung infection or a liver infection separately, without understanding there may be a common denominator behind infection in any given organ.
After Pasteur established the germ theory of disease, scientists began to realize that a pathogen—be it a bacteria or a virus—can cause infections anywhere in the body. Based on that, we no longer focus solely on treating the organ, but on addressing the underlying disease.
Today, we are shifting how we think about cancer treatment in the same way.
Whereas in the past we thought about how to treat lung cancer or liver cancer, with a different strategy depending on where it is in the body, now we’re generating data and conducting research that will give us insights into the genetic biomarkers in tumors.
Ultimately, we seek to understand the biology of the disease, to better understand why and how our medicines work.